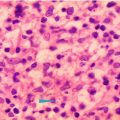

Figure 27.1
H&E 100×, Coccidiodomycosis, inflammation with scattered multinucleated giant cells
Coccidioidomycosis does not affect all ethnicities equally. Those of African, Filipino, Mexican or Native American heritage are more likely to contract the disease. Those of African descent are more likely to develop bone involvement of the disease and Filipinos are more prone to develop fungal meningitis. The reason for this predisposition is still unknown. The majority of infected individuals, approximately 60 %, are either asymptomatic or present with nonspecific symptoms similar to an upper respiratory infection. In these cases, spontaneous remission may occur within 2 weeks with complete recovery. The remaining 40 % of people will develop cough, night sweats, lethargy, anorexia and arthralgia that is referred to as “desert rheumatism.” Disseminated disease involves the bones, skin, and meninges. Coccidioidomycosis tends to occur in individuals with occupations that require field labor like construction workers and farmers.
The diagnosis of coccidioidomycosis can be made using histopathology, culture, serology and imaging studies. Under the microscope, coccidioidomycosis appears as a large spherule filled with endospores that are highlighted with either PAS or silver staining (Fig. 27.2). Cultures of pus, broncho-alveolar sputum (Figs. 27.3 and 27.4), and synovial fluid provide the best results but are dependent on the extent of dissemination. Cultures of blood, pleural fluid, and cerebral spinal fluid can be used but are generally less sensitive. Serology is performed to check for elevated serum complement-fixing antibody (CFA) titers. Titers greater than 1:32 indicate disseminated disease. In cases of meningitis, the serology CFA will be low in the blood but positive in the cerebral spinal fluid. Enzyme-linked immunosorbent assay (ELISA) is used to tag 33-kDa antigens and monitor for disease progression and response to treatment. Chest radiography is used to screen for pulmonary disease and may demonstrate hilar adenopathy, pleural effusion, infiltrates, and thin-walled cavities that remain after primary infection.